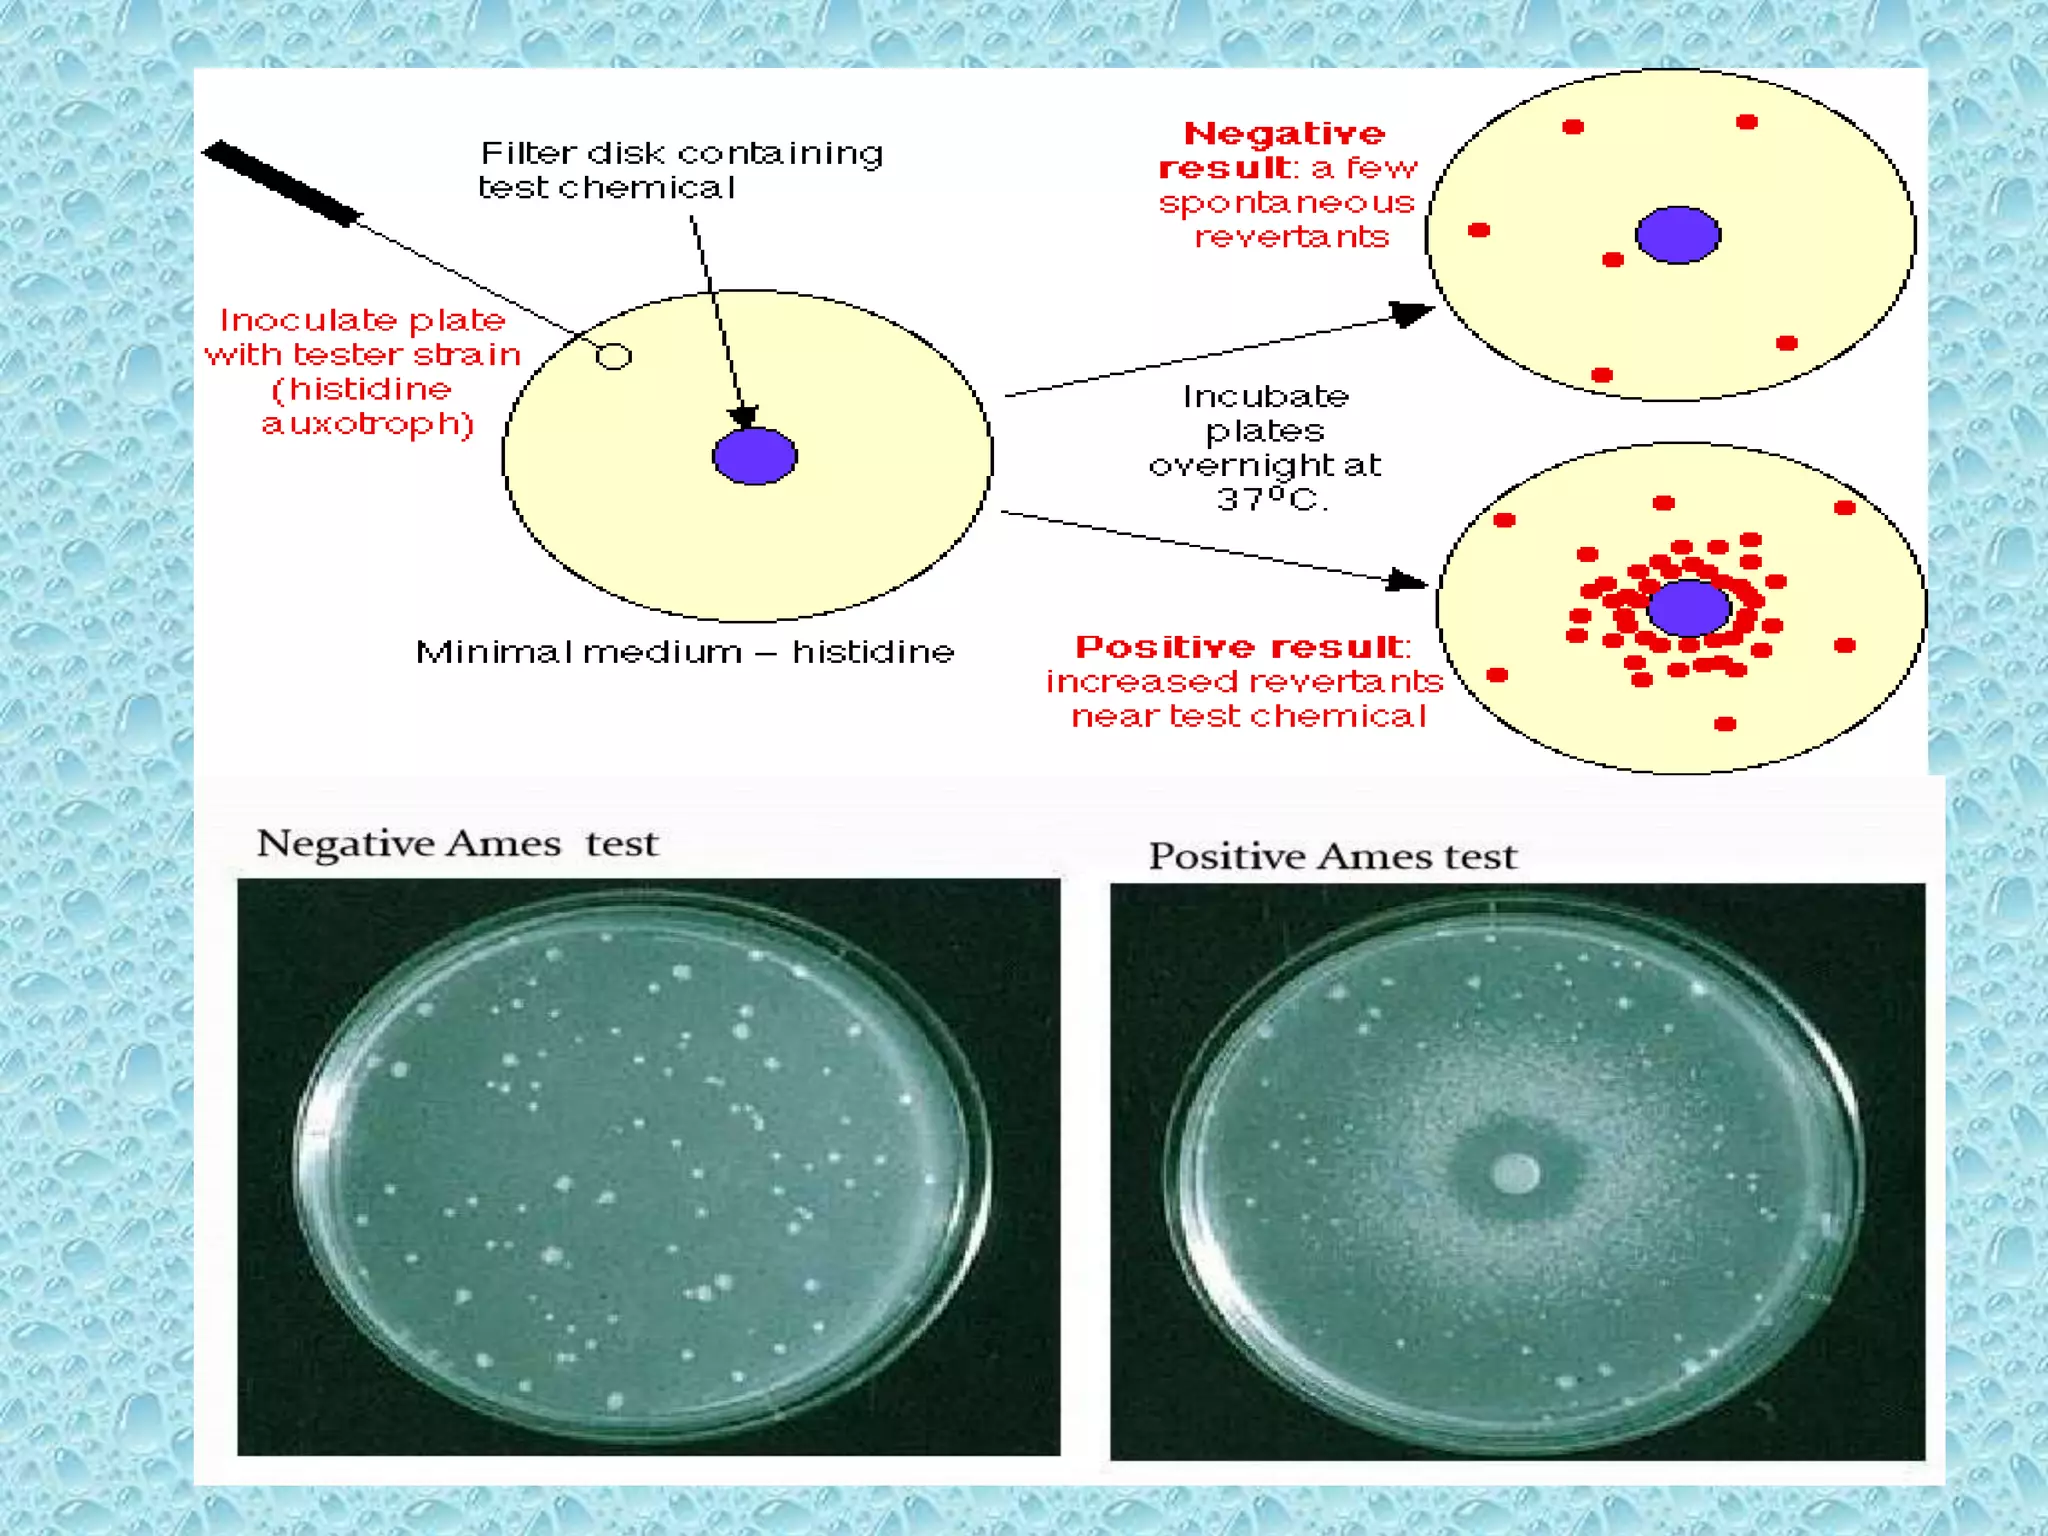

This document provides information about genotoxicity studies and various genotoxicity testing methods. It discusses that genotoxicity tests identify compounds that cause genetic damage through DNA damage or interference with the cell cycle. The standard battery of genotoxicity tests includes the Ames test (bacterial reverse mutation assay), in vitro mammalian cell micronucleus assay, in vitro mammalian chromosomal aberration assay, and in vivo mammalian erythrocyte micronucleus test, which detect various types of genetic damage. The document outlines the key principles, procedures, and reporting requirements for each of these standard genotoxicity assays.







![OECD GUIDELINES
• Genetic Toxicology : was first published in
1987 .Following a global update of the Genetic
Toxicology [1997,2013,2014,2015,2016]
• Latest revision provides :
(1) general background and historical
information on the OECD genetic toxicology.
(2) a brief overview of the important types of
genetic damage evaluated by these tests.
(3) a description of the specific tests.](https://image.slidesharecdn.com/genotoxicitystudiesaccordingtooecdguildline-180417061330/75/Genotoxicity-studies-according-to-oecd-guildline-8-2048.jpg)

















![Pre-incubation method
• Pre-incubated with the test strain .
• 0.05-0.1ml (approx. 108 cells) & sterile buffer or
the metabolic activation system (s9 0.5 ml)
usually for 20 min @30-37°c [aeration+ shaker –
48 to 72hrs]
• Mix overlay agar (2ml) and pouring onto the
surface of a minimal agar plate
• Report number of revertant colonies per plate
• ( with +ve & -ve coloies nos)
• Standard deviation](https://image.slidesharecdn.com/genotoxicitystudiesaccordingtooecdguildline-180417061330/75/Genotoxicity-studies-according-to-oecd-guildline-26-2048.jpg)

![• Bone marrow cells are usually obtained from
the femurs or tibias immediately after sacrifice
, and stained using established methods.
• Blood :tail vein or other appropriate blood
vessel , smear preparations are made and then
stained
• DNA specific stain [e.g acridine orange or
Hoechst 33258 plus pyronin-Y]](https://image.slidesharecdn.com/genotoxicitystudiesaccordingtooecdguildline-180417061330/75/Genotoxicity-studies-according-to-oecd-guildline-54-2048.jpg)





